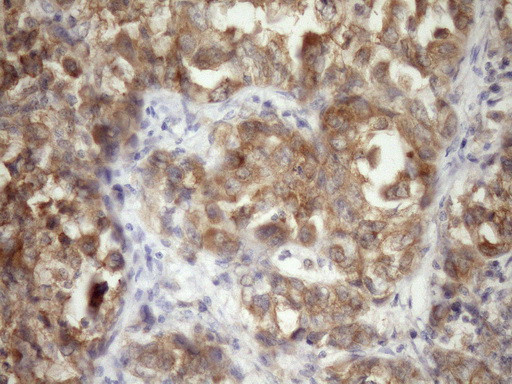
TARBP2 Antibody in Immunohistochemistry (Paraffin) (IHC (P))

Search
OriGene
TARBP2 Monoclonal Antibody (OTI7C1), TrueMAB™
{{$productOrderCtrl.translations['antibody.pdp.commerceCard.promotion.promotions']}}
{{$productOrderCtrl.translations['antibody.pdp.commerceCard.promotion.viewpromo']}}
{{$productOrderCtrl.translations['antibody.pdp.commerceCard.promotion.promocode']}}: {{promo.promoCode}} {{promo.promoTitle}} {{promo.promoDescription}}. {{$productOrderCtrl.translations['antibody.pdp.commerceCard.promotion.learnmore']}}
产品信息
TA808481
种属反应
宿主/亚型
分类
类型
克隆号
抗原
偶联物
形式
浓度
规格
纯化类型
保存液
内含物
保存条件
运输条件
靶标信息
TRBP belongs to the family of dsRNA-binding proteins. It consists of highly conserved 2 dsRNA-binding domains and C-terminal basic region. It is a unique cellular protein capable of binding to HIV-TAR RNA and stimulates expression of HIV-1 long terminal repeats. It also inhibits the host antiviral and anti-proliferative mechanisms by directly binding to IFN-regulated dsRNA-dependent protein kinase (PKR). TRBP associates with Ago2 protein and forms an integral component of Dicer-containing complex. It has a role in micro RNA processing and in RISC assembly. Other functions of TRBP include promoting cellular growth and tumorigenesis.
仅用于科研。不用于诊断过程。未经明确授权不得转售。
篇参考文献 (0)
生物信息学
蛋白别名: RISC-loading complex subunit TARBP2; TAR (HIV) RNA-binding protein 2; TAR (HIV) RNA-binding protein TRBP1; TAR (HIV-1) RNA binding protein 2; TAR RNA binding protein 2; TAR RNA-binding protein 2; TARBP2, RISC loading complex RNA binding subunit; trans-activation responsive RNA-binding protein; Trans-activation-responsive RNA-binding protein; unnamed protein product
基因别名: LOQS; TARBP2; TRBP; TRBP1; TRBP2
UniProt ID: (Human) Q15633
Entrez Gene ID: (Human) 6895